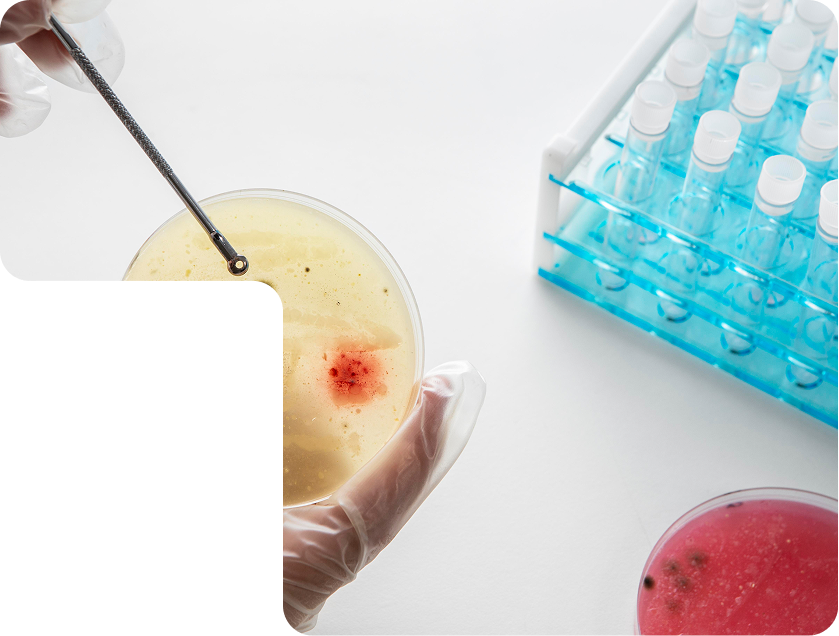

If chronic pain or injury is limiting your lifestyle, Stem Cell Therapy at Embody Wellness may be the solution you’ve been searching for. Our advanced stem cell treatments are designed to naturally promote healing, reduce pain, and restore mobility. Whether you’re suffering from knee pain, hip pain, back pain, neck pain, or shoulder pain, we provide personalized therapies that target the root cause of your discomfort.
Stem Cell Therapy is an effective treatment for both men and women who are looking for an alternative to surgery and long-term pain medications. Whether you’re dealing with the aftereffects of an injury, aging joints, or chronic musculoskeletal conditions, stem cell therapy can provide lasting relief by encouraging the body’s natural healing processes.
Repairs tissue and reduces inflammation with your body’s own cells.
Minimally invasive with
minimal downtime.
Helps you achieve long-term
weight loss success.
Repairs tissue and reduces inflammation with your
body’s own cells.
Minimally invasive with
minimal downtime.
Personalized plans for
optimal healing.

Stem cells are unique due to their ability to regenerate and repair damaged tissues. In stem cell therapy, we inject these regenerative cells into the affected area, where they stimulate tissue repair, reduce inflammation, and promote healing at a cellular level.
This treatment offers a natural solution, focusing on healing damaged tissues instead of just masking pain like traditional treatments. The result? Significant improvement in function, pain reduction, and overall mobility.
At Embody Wellness, we provide a range of stem cell therapies tailored to your specific pain needs. Each treatment is designed to target the affected area, stimulating healing and reducing pain.
Knee pain can be caused by conditions such as arthritis or injury. Stem cell therapy promotes cartilage regeneration, easing pain and improving joint function.
Hip pain can make simple tasks feel difficult. Whether due to arthritis or injury, our stem cell treatments target the hip joint, helping reduce pain and enhance mobility for a pain-free life.
Back pain is one of the most common complaints we treat. Stem cell therapy works to regenerate tissues in the spine, reduce inflammation, and improve mobility.
Neck pain can result from poor posture, injury, or arthritis. With stem cell therapy, we can help heal damaged tissues and alleviate pain, providing lasting relief and improved range of motion.
Shoulder pain, whether from rotator cuff tears, arthritis, or tendonitis, can limit your ability to move freely. Stem cell therapy repairs and regenerates the shoulder joint, reducing pain and restoring strength and function.

If you’re ready to regain control of your life and say goodbye to chronic pain, Stem Cell Therapy at Embody Wellness is the solution. Our personalized treatments can help you heal naturally, with lasting results. Book an Appointment now to discover how stem cell therapy can help you restore your health and enjoy life without pain.